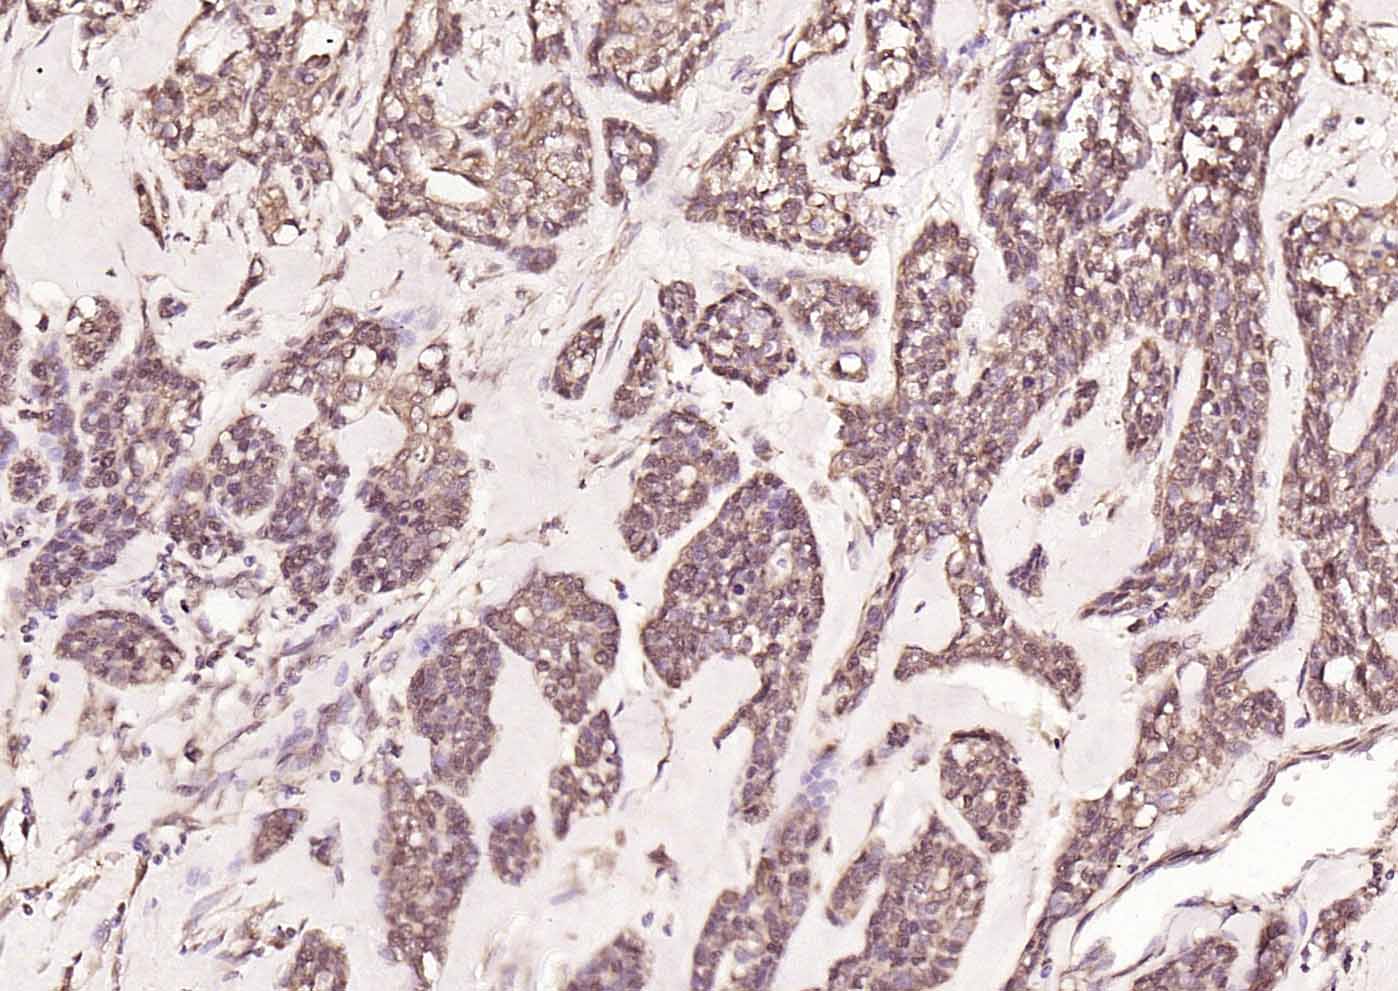
产品细节图片7

相关产品推荐更多 >

HMGB1 Rabbit pAb, PerCP conjugated(bs-0664R-PerCP)-100ul
¥2980
Parvalbumin Rabbit pAb, BF750 conjugated(bs-1299R-BF750)-100ul
¥2980
Annexin A1 Rabbit pAb, PE-Cy5 conjugated(bs-1562R-PE-Cy5)-100ul
¥2980
PCNA Mouse mAb, Cy5 conjugated(bsm-33035M-Cy5)-100ul
¥2980
Hepcidin-25 Rabbit pAb(bs-8870R)-50ul/100ul/200ul
¥1180
万千商家帮你免费找货
0 人在求购买到急需产品
- 详细信息
- 文献和实验
- 技术资料
- 应用范围:
产品信息以Bioss网站为准
- 规格:
50ul/100ul/200ul
| 规格: | 50ul | 产品价格: | ¥1180.0 |
|---|---|---|---|
| 规格: | 100ul | 产品价格: | ¥1980.0 |
| 规格: | 200ul | 产品价格: | ¥2800.0 |
| 产品编号 | bs-1813R |
| 英文名称 | HDAC2 Rabbit pAb |
| 中文名称 | 组蛋白去乙酰化酶2抗体 |
| 英文别名 | histone deacetylase 2; D10Wsu179e; EC 3.5.1.98; HD2; HDAC 2; Hdac2; histone deacetylase 2; RPD3; transcriptional regulator homolog RPD3; YAF1; YY1 associated factor 1; YY1 transcription factor binding protein; Yy1bp; HDAC2_HUMAN. |
| 产品应用 | IHC-P=1:100-500, IHC-F=1:100-500, IF=1:100-500 Not yet tested in other applications. |
| 交叉反应 | Human, Mouse, Rat (Chicken, Pig, Cow, Horse) |
| 抗体来源 | Rabbit |
| 免疫原 | KLH conjugated synthetic peptide derived from human HDAC2 |
| 亚型 | IgG |
| 性状 | Liquid |
| 纯化方法 | affinity purified by Protein A |
| 克隆类型 | Polyclonal |
| 理论分子量 | 53 kDa |
| 浓度 | 1mg/ml |
| 储存液 | 0.01M TBS (pH7.4) with 1% BSA, 0.02% Proclin300 and 50% Glycerol. |
| 研究领域 | Cardiovascular > Heart > Hypertrophy Epigenetics and Nuclear Signaling > Chromatin Modifying Enzymes > Acetylation Epigenetics and Nuclear Signaling > Chromatin Modifying Enzymes > Acetylation > HDACs > Class I Stem Cells > Signaling Pathways > Wnt > HDACs |
| 亚基 | Component of a RCOR/GFI/KDM1A/HDAC complex. Interacts directly with GFI1 and GFI1B. Interacts with SNW1, HDAC7, PRDM6, SAP30, SETDB1 and SUV39H1. Interacts with the H2AFY (via the non-histone region) (By similarity). Part of the core histone deacetylase (HDAC) complex composed of HDAC1, HDAC2, RBBP4 and RBBP7. The core complex associates with MTA2, MBD3, MTA1L1, CHD3 and CHD4 to form the nucleosome remodeling and histone deacetylation (NuRD) complex, or with SIN3, SAP18 and SAP30 to form the SIN3 HDAC complex. Component of a BHC histone deacetylase complex that contains HDAC1, HDAC2, HMG20B, KDM1A, RCOR1 and PHF21A. The BHC complex may also contain ZMYM2, ZNF217, ZMYM3, GSE1 and GTF2I. Part of a complex containing the core histones H2A, H2B, H3 and H4, DEK and unphosphorylated DAXX. Part of a complex containing ATR and CHD4. Forms a heterologous complex at least with YY1. Interacts with ATR, CBFA2T3, DNMT1, MINT, HDAC10, HCFC1, NRIP1, KDM4A and PELP1. Component of a mSin3A corepressor complex that contains SIN3A, SAP130, SUDS3, ARID4B, HDAC1 and HDAC2. Interacts with CHFR and SAP30L. Interacts (CK2 phosphorylated form) with SP3. Interacts with TSHZ3 (via its N-terminus). Interacts with APEX1; the interaction is not dependent on the acetylated status of APEX1. Part of a complex composed of TRIM28, HDAC1, HDAC2 and EHMT2. |
| 亚细胞定位 | Nucleus. |
| 组织特异性 | Widely expressed; lower levels in brain and lung. |
| 翻译后修饰 | S-nitrosylated by GAPDH. In neurons, S-Nitrosylation at Cys-262 and Cys-274 does not affect the enzyme activity but abolishes chromatin-binding, leading to increases acetylation of histones and activate genes that are associated with neuronal development. In embryonic cortical neurons, S-Nitrosylation regulates dendritic growth and branching. |
| 相似性 | Belongs to the histone deacetylase family. HD type 1 subfamily. |
| 功能 | Responsible for the deacetylation of lysine residues on the N-terminal part of the core histones (H2A, H2B, H3 and H4). Histone deacetylation gives a tag for epigenetic repression and plays an important role in transcriptional regulation, cell cycle progression and developmental events. Histone deacetylases act via the formation of large multiprotein complexes. Forms transcriptional repressor complexes by associating with MAD, SIN3, YY1 and N-COR. Interacts in the late S-phase of DNA-replication with DNMT1 in the other transcriptional repressor complex composed of DNMT1, DMAP1, PCNA, CAF1. Deacetylates TSHZ3 and regulates its transcriptional repressor activity. Component of a RCOR/GFI/KDM1A/HDAC complex that suppresses, via histone deacetylase (HDAC) recruitment, a number of genes implicated in multilineage blood cell development. |
| 保存条件 | Shipped at 4℃. Store at -20℃ for one year. Avoid repeated freeze/thaw cycles. |
| 注意事项 | This product as supplied is intended for research use only, not for use in human, therapeutic or diagnostic applications. |
| 背景资料 | This gene product belongs to the histone deacetylase family. Histone deacetylases act via the formation of large multiprotein complexes, and are responsible for the deacetylation of lysine residues at the N-terminal regions of core histones (H2A, H2B, H3 and H4). This protein forms transcriptional repressor complexes by associating with many different proteins, including YY1, a mammalian zinc-finger transcription factor. Thus, it plays an important role in transcriptional regulation, cell cycle progression and developmental events. Alternative splicing results in multiple transcript variants. [provided by RefSeq]. |
| 应用 | 推荐稀释比例 |
| {IHC-P} | {1:100-500} |
| {IHC-F} | {1:100-500} |
| {IF} | {1:100-500} |

风险提示:丁香通仅作为第三方平台,为商家信息发布提供平台空间。用户咨询产品时请注意保护个人信息及财产安全,合理判断,谨慎选购商品,商家和用户对交易行为负责。对于医疗器械类产品,请先查证核实企业经营资质和医疗器械产品注册证情况。
 文献和实验
文献和实验[IF={{ 2.1 }}] {Zhenjie Huang. et al. Protective effects of different anti‑inflammatory drugs on tracheal stenosis following injury and potential mechanisms. Mol Med Rep. 2021 May;23(5):1-11} {WB,IF} {Rabbit}
[IF={{ 1.785 }}] {Zhenjie Huang. et al. Expression of histone deacetylase 2 in tracheal stenosis models and its relationship with tracheal granulation tissue proliferation. Exp Ther Med. 2021 May;21(5):1-10} {IF} {Rabbit}
= NAL), appears to form upon oxidative cyclization of the nonfluorescent 2:1 lysine-HNE Michael adduct-Schiff base cross-link (Scheme 1). Polyclonal antibody (PAb) to the NAL-HNE fluorophore was raised in rabbit and found to be highly specific
GE Healthcare Benzamidine Sepharose™ 6B is p-aminobenzamidine covalently attached to Sepharose 6B by the epoxy coupling method. p-Aminobenzamidine (PAB), is a synthetic inhibitor of trypsin-like serine protease. Trypsin and trypsin
Overview of Receptor Allosterism
on its molecular weight. J. Physiol. 39:411‐428. Black, J.W. and Leff, P. 1983. Operational models of pharmacological agonism. Proc. R. Soc. Lond. B. Biol. Sci. 220:141‐162
 技术资料
技术资料暂无技术资料 索取技术资料





